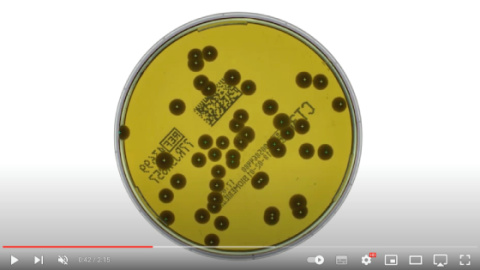

Показано: 12 из 34

Распаковка гомогенизатора JumboMix 3500 W CC, Interscience, англ., 2025 г.
07.06.2025

Распаковка гомогенизатора BagMixer 400 SW, Interscience, англ., 2025 г.
07.06.2025

Распаковка гомогенизатора BagMixer 400 CC, Interscience, англ., 2025 г.
07.06.2025

Обзор лопаточных гомогенизаторов серии BagMixer 400, Interscience, англ., 2025 г.
07.06.2025

Процесс гомогенизации куска пиццы с помощью BagMixer 400 SW, Interscience, англ., 2025 г.
05.02.2025

Автоматизированная роботизированная система инкубации, детекции и подсчета колоний ScanStation, Intersience, англ., 2023 г.
04.09.2024

Автоматизированная роботизированная система инкубации, детекции и подсчета колоний ScanStation 100, Intersience, англ., 2024 г.
22.08.2024

Автоматизация микробиологической лаборатории, Interscience, англ., 2023 г.
03.10.2023
Пример использования ScanStation на косметическом производстве, Interscience, англ., 2020 г.
03.10.2023

ScanStation – роботизированный инкубатор и счетчик колоний в реальном времени, Interscience, англ., 2020 г.
03.10.2023

Принтер полуавтоматический для маркировки чашек Петри и отслеживания этапов анализа dataLink pro, Interscience, англ., 2022 г.
06.09.2023

Подготовка и анализ образца в микробиологической лаборатории. Решения от Intersciences, англ., 2023 г.
03.08.2023